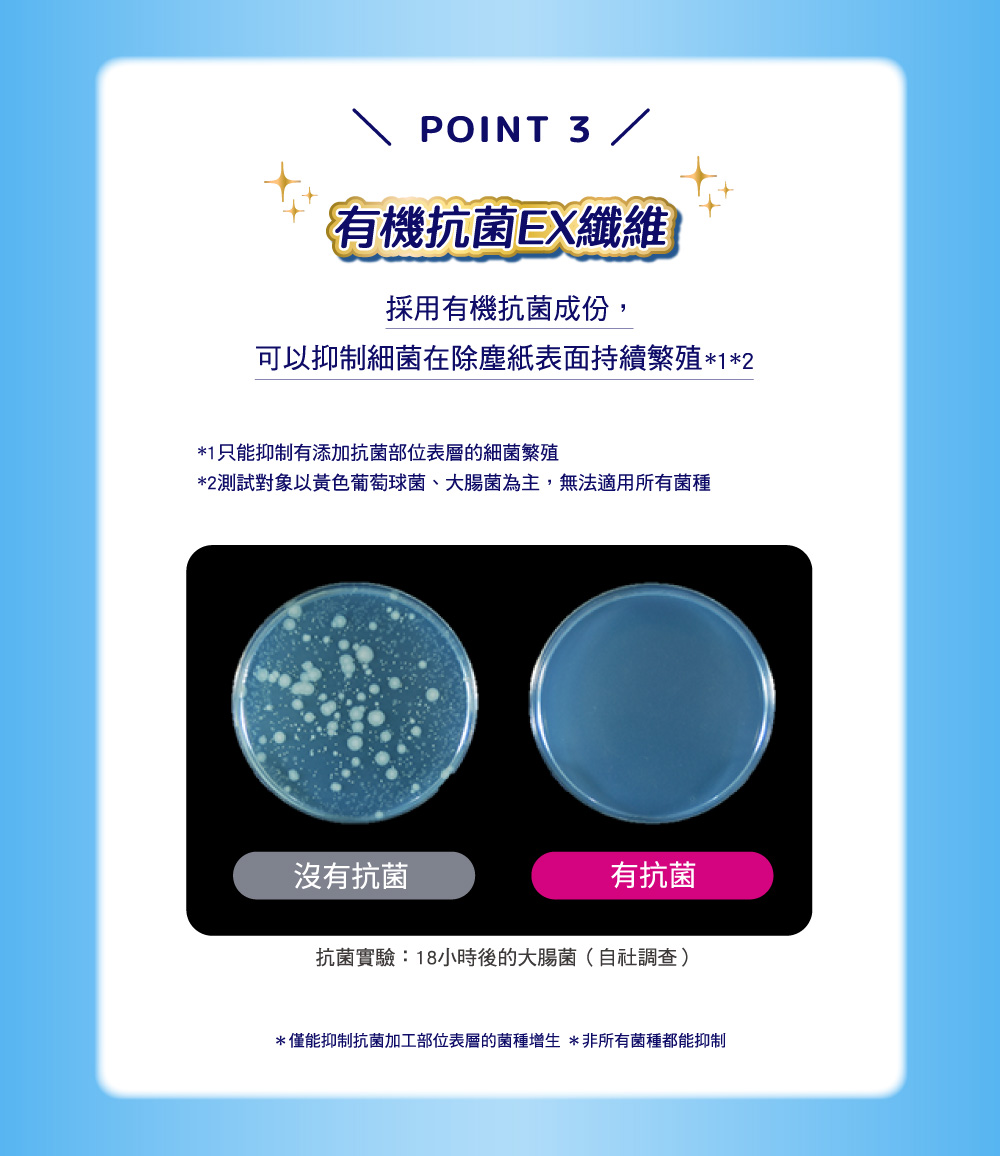

$ 71
$ 71 特價
贈點
指定支付★滿1500送1000點
2026/06/03 贈點
- 商品說明
- 退貨&注意事項
詳細說明

.
.
商品特色
• 200個立體集塵凹槽
• 40萬根立體除塵纖維
• 餅乾碎屑都能有效抓取不殘留
商品規格
品名 / 威拂 超保水濕拖巾/除塵紙補充包
規格 / 青檸柑橘 12片
成分&材質 / 縲縈等不織布、水、界面活性劑、除菌劑、香料
產地 / 台灣
保存期限 / 詳見產品包裝標示
保存方法 / 請放置於乾燥陰涼處,避免太陽直射常溫保存,開封後請冷藏並儘快食用完畢
注意事項 / 詳見產品包裝標示
製造廠商或國內負責廠商名稱 / 嬌聯股份有限公司
製造廠商或國內負責廠商地址 / 新北市板橋區新站路16號25樓
製造廠商或國內負責廠商電話 / 02-2382-5678
◎ 製造日期與有效期限,成分皆標示於包裝盒上
◎ 本產品網頁因拍攝關係,圖檔略有差異,實際以廠商出貨為主
◎ 本產品文案若有變動敬請參照實際商品為準
◎ 以消費者收受日算起,至少距有效日期前【30】日以上:依商品包裝標示,若收到小於30天可聯絡客服供退換貨

全聯實業股份有限公司版權所有
客服:02-8175-1008
地址:臺北市中山區敬業四路33號
使用條款&使用者權益 more
